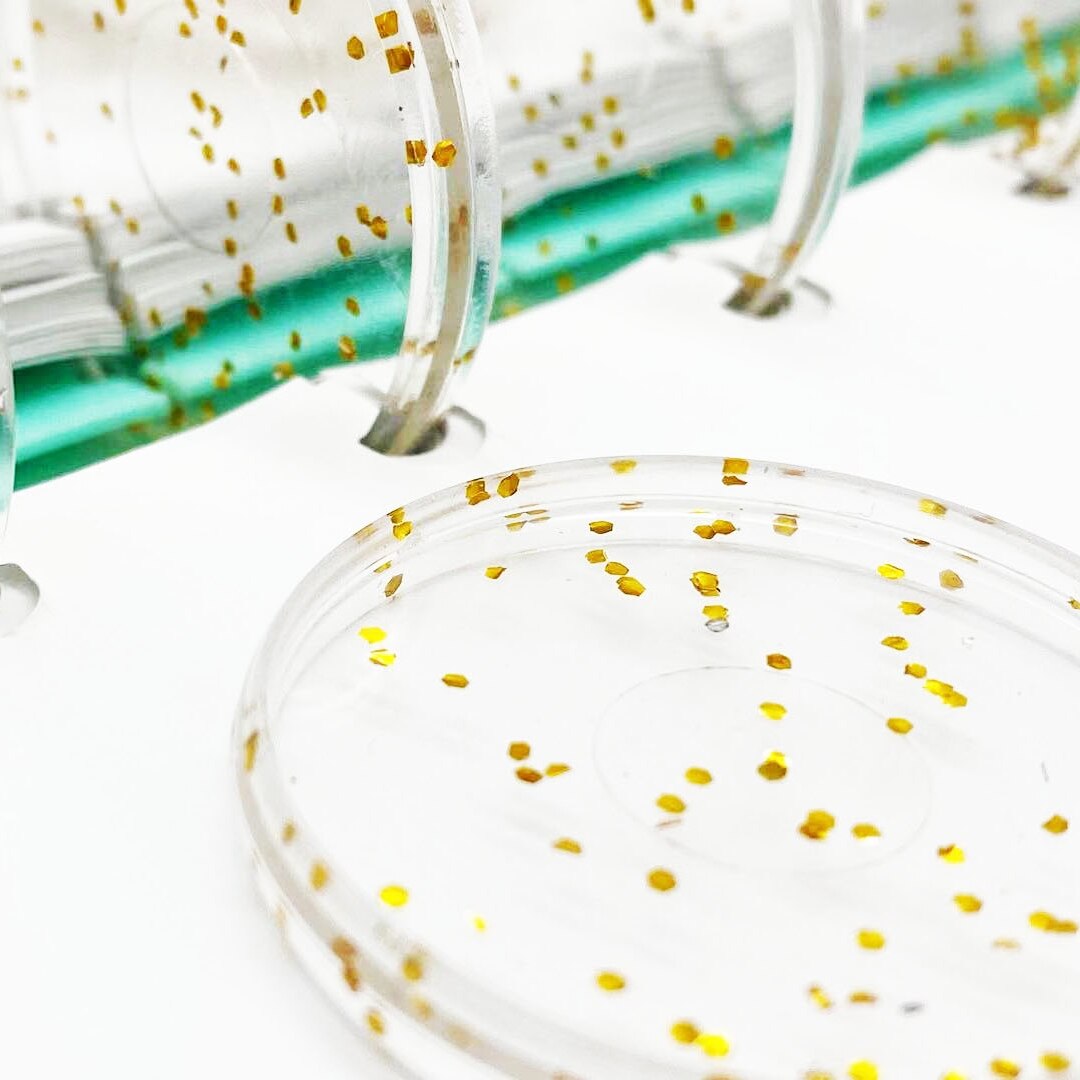
50pcs 38mm Book Binding Supplies Plastic Binding Discs Mushroom Hole Binder Flash Point Disc Binding Loose-leaf Ring

- Free shipping
- 100 days returns
- Low prices
- 5 million products
50pcs 38mm Book Binding Supplies Plastic Binding Discs Mushroom Hole Binder Flash Point Disc Binding Loose-leaf Ring
Specifications:
- Specifications: External diameter 38mm
- Single weight: About1g
- Punching Quantity: Other
- Punching Mode: Other
- Model: 38mm
- Brand Name: LZN

- Free shipping
- 100 days returns
- Low prices
- 5 million products